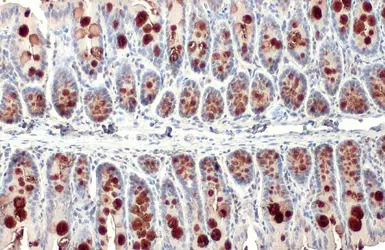
产品细节图片3

研选同类产品更多 >
万千商家帮你免费找货
0 人在求购买到急需产品
- 详细信息
- 用户评价
- 文献和实验
- 技术资料
- 免疫原:
Carrier-protein conjugated synthetic peptide encompassing a sequence within the C-terminus region of human MUC2. The exact sequence is proprietary.
- 亚型:
IgG
- 形态:
Liquid
- 保存条件:
Store as concentrated solution. Centrifuge briefly prior to opening vial. For short-term storage (1-2 weeks), store at 4ºC. For long-term storage, aliquot and store at -20ºC or below. Avoid multiple freeze-thaw cycles.
- 克隆性:
Polyclonal
- 标记物:
Unconjugated
- 适应物种:
Human, Mouse, Rat
- 保质期:
12 months from the shipping date of the product.
- 抗原来源:
Human
- 目录编号:
GTX100664
- 级别:
Primary Antibodies
- 库存:
Available
- 供应商:
GeneTex
- 宿主:
Rabbit
- 应用范围:
WB, ICC/IF, IHC-P, IHC-Fr, FISH, IHC
- 浓度:
1 mg/ml (Please refer to the vial label for the specific concentration.)
- 靶点:
MUC2
- 抗体英文名:
MUC2 antibody [C3], C-term
- 抗体名:
MUC2 抗体 [C3], C-term
- 规格:
100 μl/25 μl
| 规格: | 100 μl | 产品价格: | ¥4000.0 |
|---|---|---|---|
| 规格: | 25 μl | 产品价格: | ¥1700.0 |

MUC2 antibody [C3], C-term detects secreted MUC2 protein by immunohistochemical analysis.
Sample: Paraffin-embedded mouse intestine.
MUC2 stained by MUC2 antibody [C3], C-term (GTX100664) diluted at 1:500.
Antigen Retrieval: Citrate buffer, pH 6.0, 15 min

MUC2 antibody [C3], C-term detects secreted MUC2 protein by immunohistochemical analysis.
Sample: Paraffin-embedded mouse colon.
MUC2 stained by MUC2 antibody [C3], C-term (GTX100664) diluted at 1:500.
Antigen Retrieval: Citrate buffer, pH 6.0, 15 min
MUC2 antibody [C3], C-term detects secreted MUC2 protein by immunohistochemical analysis.
Sample: Paraffin-embedded mouse colon.
MUC2 stained by MUC2 antibody [C3], C-term (GTX100664) diluted at 1:500.
Antigen Retrieval: Citrate buffer, pH 6.0, 15 min

MUC2 antibody [C3], C-term detects secreted MUC2 protein by immunohistochemical analysis.
Sample: Paraffin-embedded mouse intestine.
MUC2 stained by MUC2 antibody [C3], C-term (GTX100664) diluted at 1:500.
Antigen Retrieval: Citrate buffer, pH 6.0, 15 min

MUC2 antibody [C3], C-term detects secreted MUC2 protein in human intestine by immunohistochemical analysis.
Sample: Paraffin-embedded human intestine.
MUC2 antibody [C3], C-term (GTX100664) diluted at 1:750.
Antigen Retrieval: Citrate buffer, pH 6.0, 15 min
风险提示:丁香通仅作为第三方平台,为商家信息发布提供平台空间。用户咨询产品时请注意保护个人信息及财产安全,合理判断,谨慎选购商品,商家和用户对交易行为负责。对于医疗器械类产品,请先查证核实企业经营资质和医疗器械产品注册证情况。
 用户评价
用户评价 暂无用户评价
暂无用户评价 文献和实验
文献和实验Application Reference
- Baghdadi et al., Science 2024 386 (PMID:39607940)
- Hwang D et al., J Funct Foods 2017 35()
- Wang K et al., Immunity 2014 (PMID:25526314)
- Usui T et al., Stem Cells International 2016 2016()
- Grivennikov SI et al., Nature 2012 (PMID:23034650)
- Yao Y et al., Cell 2022 (PMID:35303419)
- Lin SJ et al., Front Cell Infect Microbiol 2022 (PMID:36683692)
- Liu Y et al., Front Cell Infect Microbiol 2022 (PMID:36425784)
- Ilani T et al., EMBO J 2023 (PMID:36245281)
- Torp AM et al., Appl Environ Microbiol 2022 (PMID:35758759)
- Puri P et al., Cell Mol Gastroenterol Hepatol 2022 (PMID:35690337)
- Wang Z et al., Redox Biol 2023 (PMID:36724577)
- Xu Y et al., Cell Biosci 2023 (PMID:36631841)
- He Q et al., Life Sci Alliance 2023 (PMID:36759174)
- Hye-Youn Cho et al., Toxicol Pathol 2021 (PMID:33938323)
- Feiling Song et al., Front Cell Dev Biol 2021 (PMID:34796175)
- Sharpen JDA et al., Nat Commun 2022 (PMID:35017479)
- Nishio J et al., Sci Rep 2021 (PMID:34642357)
- Gudi?o V et al., Nat Commun 2021 (PMID:33879799)
- Layunta E et al., Cell Rep 2021 (PMID:33596425)
- Miyazaki T et al., Sci Rep 2021 (PMID:33436792)
- Ma S et al., Biomolecules 2020 (PMID:32283838)
- Wang S et al., Theranostics 2020 (PMID:32929341)
- Li C et al., Res Vet Sci 2020 (PMID:32947071)
- Toubai T et al., Nat Microbiol 2019 (PMID:30858572)
- van der Hee B et al., Front Cell Dev Biol 2020 (PMID:32714922)
- Ma S et al., Sci Rep 2020 (PMID:32218552)
- Yeom J et al., Antioxidants (Basel) 2020 (PMID:32150901)
- Song S et al., Biochem Biophys Res Commun 2020 (PMID:31733832)
- Hwang D et al., Food Chem Toxicol 2018 (PMID:29935245)
- Ozcan HEA et al., Adv Med Sci 2018 (PMID:29803118)
- Jinfang et al., Digestive and Liver Disease 2018 (Epub)
- Sun C et al., Inflamm Bowel Dis 2017 (PMID:28719542)
补体成分 C3(C3a/C3b) 补体成分:C3 血清浓度(μg/ml):550-1200 分子量(kDa):195 亚单位(链)及分子量(kDa):α∶110;β∶85 激活产物:C3a;C3b 生物学活性:C3a 过敏毒素、趋化作用等。 C3b 组成CP、AP中的C3、C5转化
上海西唐生物科技有限公司 021-55229872, 65333639 www.westang.com 大鼠补体 C3(C3)ELISA 试剂盒 ( 用于血清、血浆、细胞培养上清液和生物体液内 ) 原理 本实验采用双抗体夹心 ABC-ELISA 法。用抗大鼠 C3 单抗包被于酶标板上,标准品和样品中的 C3 与单抗结合,加入生物素化的抗大鼠 C3 ,形成免疫复合物连接在板上,辣根
人补体C3 (C3)ELISA 试剂盒 ( 用于血清、血浆、细胞培养上清液和其它生物体液内 ) 原理 本实验采用双抗体夹心 ABC-ELISA 法。用抗人 C3 单抗包被于酶标板上,标准品和样品中的 C3与单抗结合,加入生物素化的抗人 C3 ,形成免疫复合物连接在板上,辣根过氧化物酶标记的 Streptavidin 与生物素结合,加入底物工作液显蓝色,最后加终止液硫酸,在 450nm 处测
 技术资料
技术资料暂无技术资料 索取技术资料






![Vinexin antibody [N3C2], Internal](https://img1.dxycdn.com/2022/0328/570/4170829812901300453-14.jpg!wh200)
![Enterovirus D68 VP3 antibody [GT1665]](https://img1.dxycdn.com/2022/0329/902/3950146594347020453-14.jpg!wh200)

![p73 antibody [5B429]](https://img1.dxycdn.com/2022/0328/857/9527819040816400453-14.jpg!wh200)
![Enterovirus D68 VP1 antibody [HL1997]](https://img1.dxycdn.com/2023/0605/423/2302796740531755661-14.jpg!wh200)

